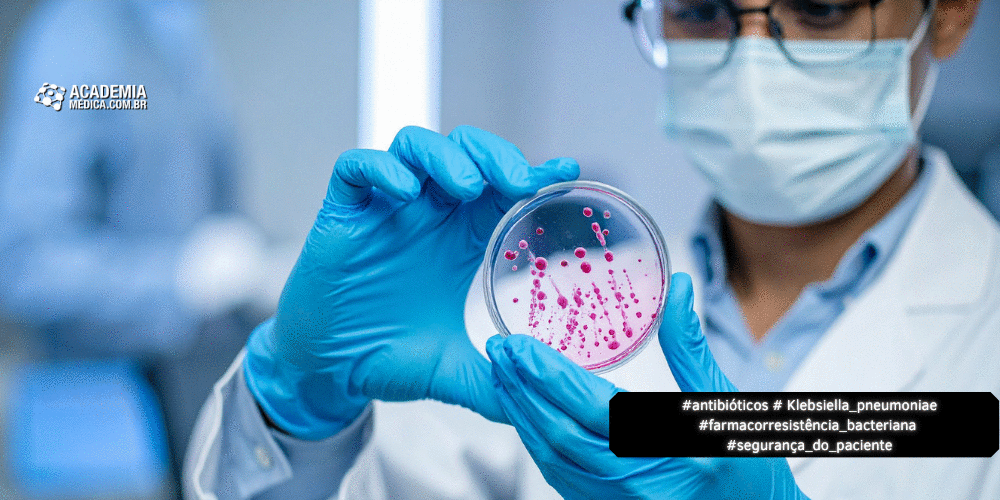
A Farmacorresistência Bacteriana

Nas últimas duas décadas, a terapia gênica passou de um campo predominantemente experimental para uma estratégia terapêutica com aplicações clínicas documentadas em condições específicas. Revisões recentes descrevem que, em doenças monogênicas
Publique vídeos, fotos e textos na Academia Médica!
Classificar por